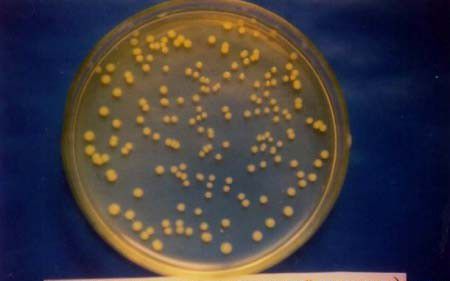
什么是菌丝及菌丝体？

什么是菌丝及菌丝体?
时间:2024-06-17 14:14:17
来源:网络
浏览:657次
什么是菌丝及菌丝体?
真菌营养生长阶段的结构,用来吸收水分和养料,进行营养增殖的菌体称为营养体。真菌的营养体除少数为单细胞(如酵母菌)外,大多数都是极为细小的丝状体每一根丝状体称为菌丝,组成真菌菌丝的一团菌丝称为菌丝体。极低等的真菌,没有丝状的菌丝体,它的营养体只不过是没有细胞壁的原质团(变形体)。
菌丝通常是圆管状,分枝不同真菌的菌丝粗细不同,一般粗细为5~6μm。幼龄菌丝一般无透明,老龄菌丝常呈现各种色泽,如褐色、棕色、紫色等。菌丝外部为细胞壁,内部为含有原生质、细胞核、液泡和油滴等内含物。细胞核很小,在营养生长阶段不很清楚,但在生殖阶段时,特别是一些较高等的真菌,细胞核就变得大而明显。
低真菌的菌丝一般没有隔膜,管状,内含许多细胞核,全体犹如一个多核的细胞,这种菌丝称为无隔菌丝或管状菌丝。
高等真菌的菌丝,有很多隔膜,分为若干菌丝细胞,每个细胞内含有一至多个核,细胞之间有孔道相通,这种菌丝称为有隔菌丝或细胞状菌丝。
一条管状菌丝或菌丝体的片段为大多数真菌的营养体单位,它在基物上或基物内向各方分枝延伸吸取养料。菌丝一般由孢子萌发后延长形成,或由一段菌丝细胞增长而成。菌丝为顶端生长。但其各部分均有潜在的生长能力,任何一段微小碎片或片段都能产生一个新的生长点,并发展成新的个体。菌丝生长是无限的。
